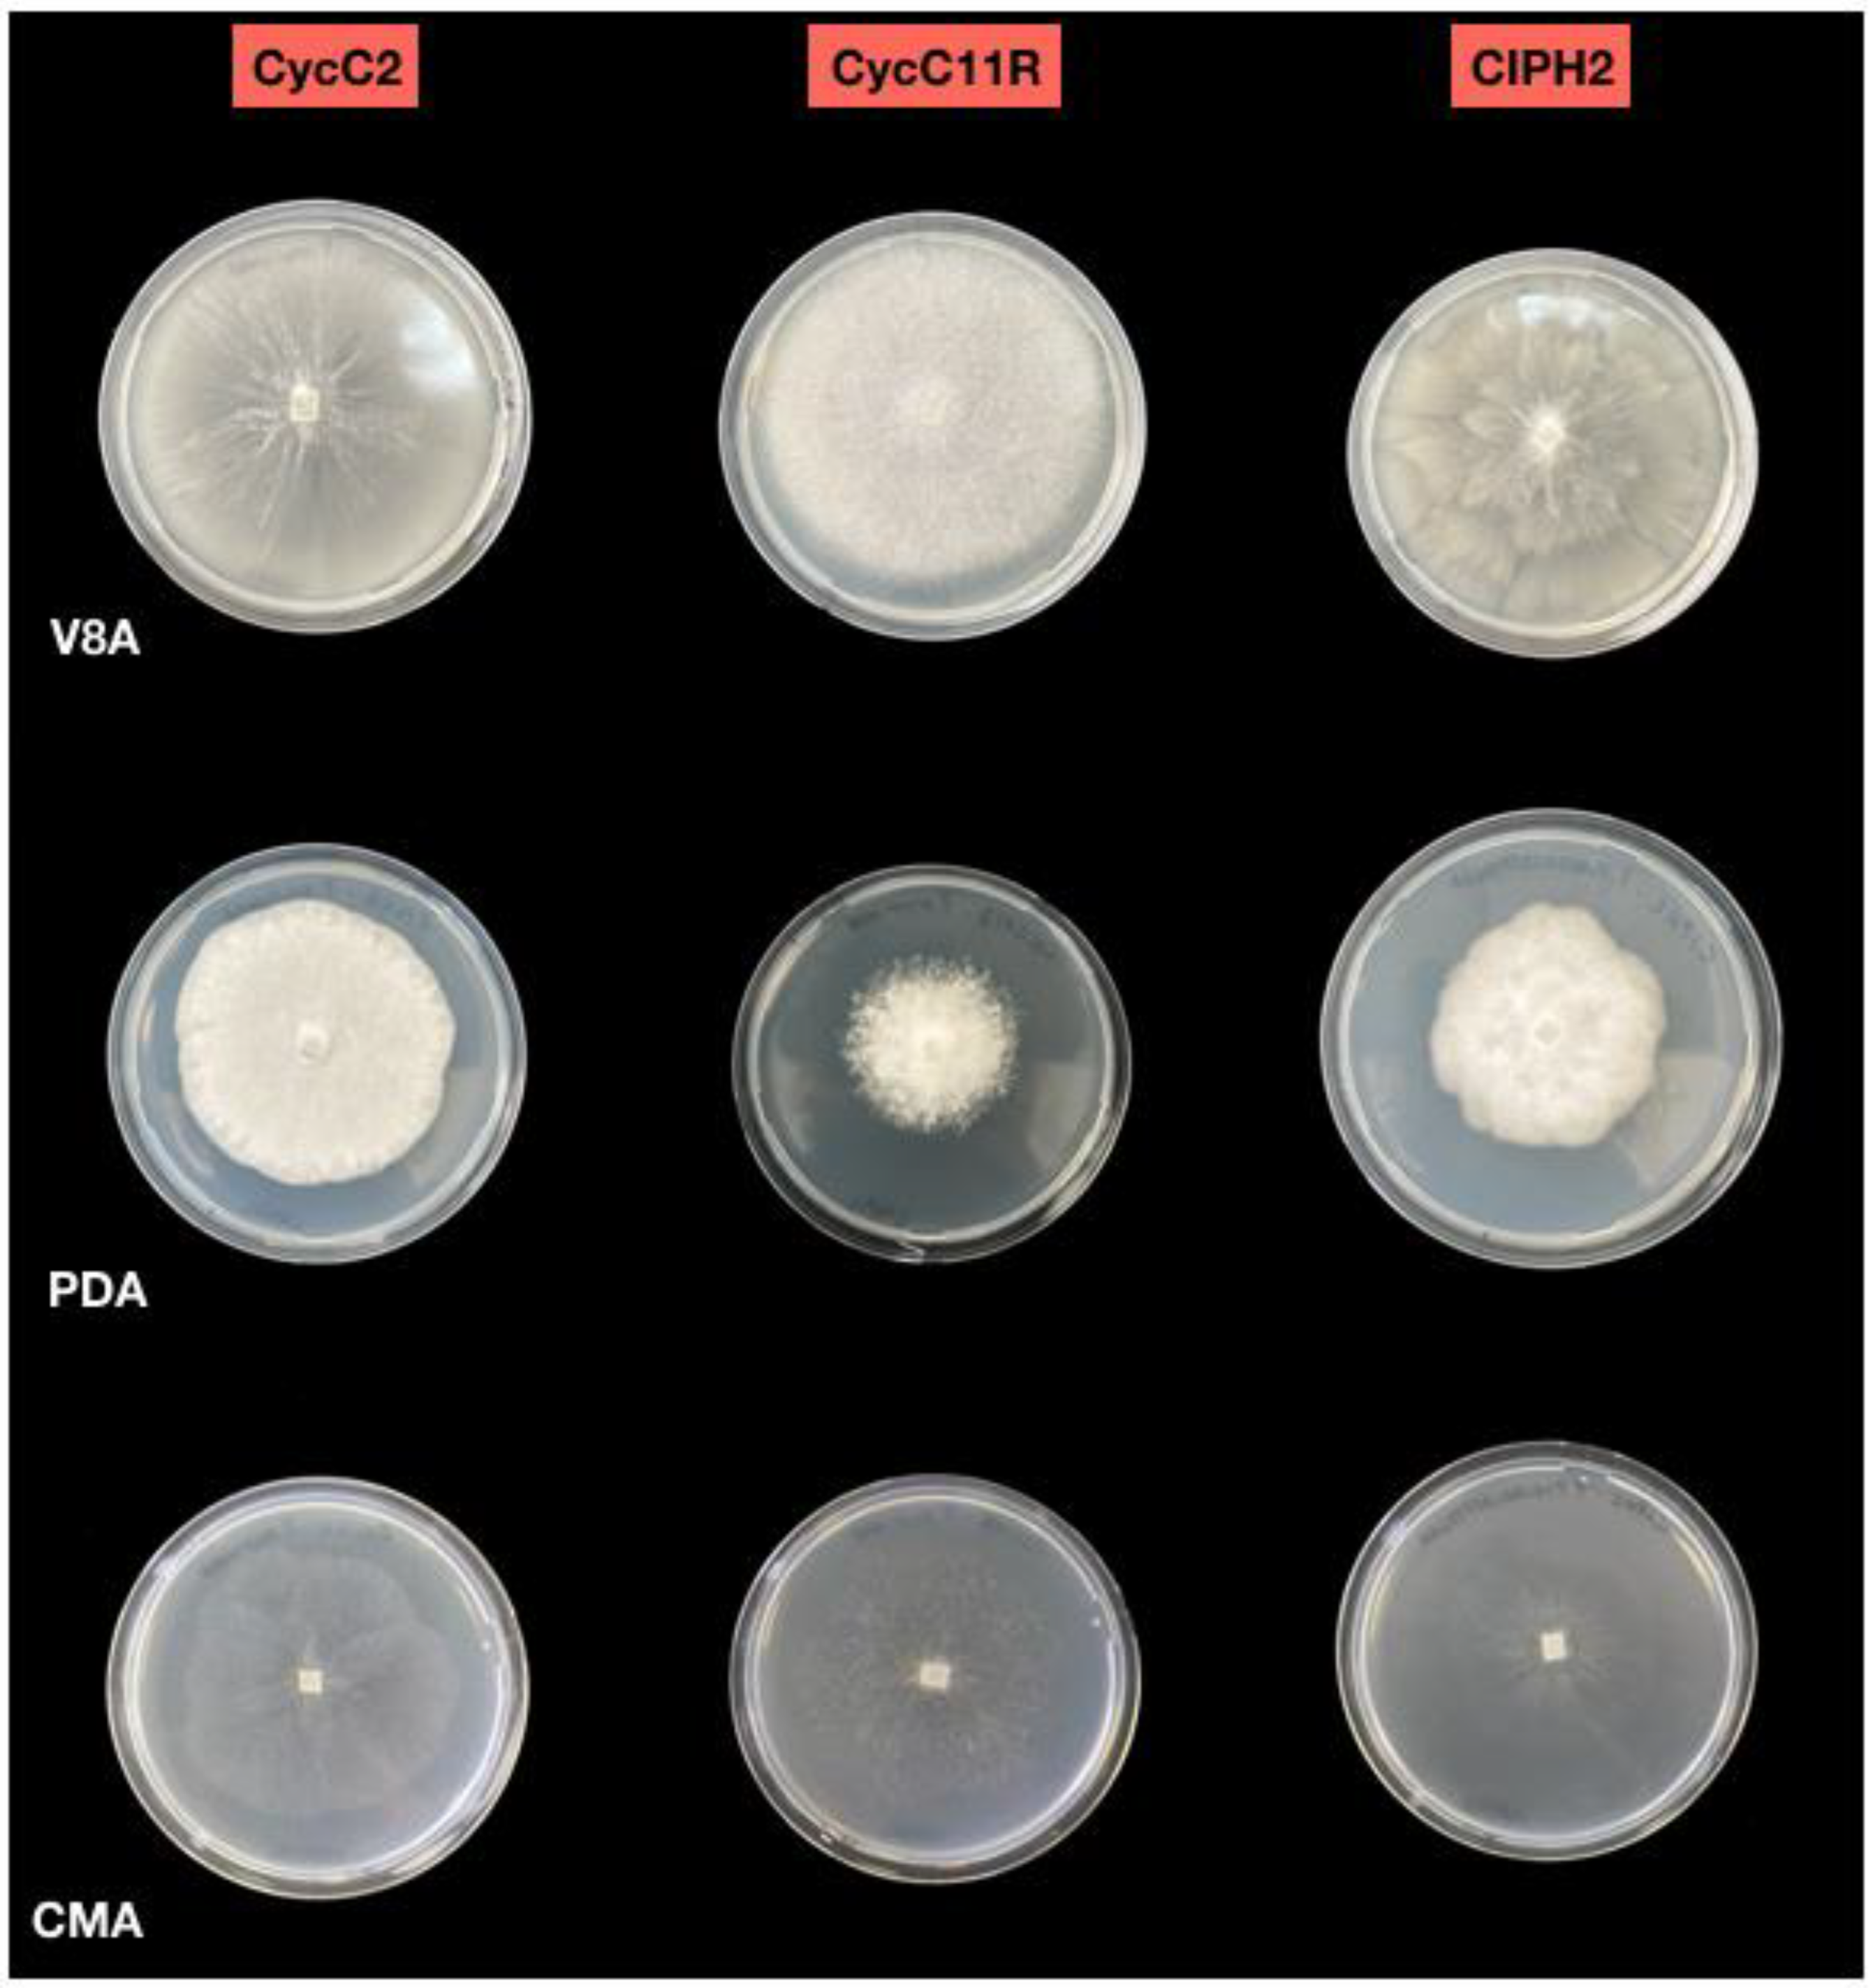
Plants 12 01197 g002

Phytophthora pseudocryptogea, P. nicotianae and P. multivora Associated to Cycas revoluta: First Report Worldwide
Abstract
:1. Introduction
2. Results
2.1. Symptoms of the Disease
2.2. Morphological Identification of Isolates
2.3. Molecular Identification
2.4. Pathogenicity Tests
3. Discussion
4. Materials and Methods
4.1. Isolation and Morphological Characterization of Isolates
4.2. Molecular Identification
4.3. Pathogenicity Tests
5. Conclusions
Author Contributions
Funding
Institutional Review Board Statement
Informed Consent Statement
Data Availability Statement
Acknowledgments
Conflicts of Interest
References
- Donaldson, J.S.; Hill., K.D.; Stevenson, D.W. Cycads of the World: An Overview. In Cycads; Donaldson, J.S., Ed.; IUCN/SSC Cycad Specialist Group: Gland, Switzerland; Cambridge, UK, 2003; pp. 3–8. [Google Scholar]
- Nagalingum, N.S.; Marshall, C.R.; Quental, T.B.; Rai, H.S.; Little, D.P.; Mathews, S. Recent synchronous radiation of a living fossil. Science 2011, 334, 796–799. [Google Scholar] [CrossRef] [PubMed]
- Mankga, L.T.; Yessoufou, K.; Mugwena, T.; Citakira, M. The cycad genus Cycas may have diversified from Indochina and occupied its current ranges through vicariance and dispersal events. Front. Ecol. Evol. 2020, 8, 44. [Google Scholar] [CrossRef] [Green Version]
- Cousins, S.R.; Williams, V.L.; Witkowski, E.T.F. Uncovering the cycad taxa (Encephalartos species) traded for traditional medicine in Johannesburg and Durban, South Africa. S. Afr. J. Bot. 2012, 78, 129–138. [Google Scholar] [CrossRef] [Green Version]
- Calonje, M.; Stevenson, D.; Osborne, R. The World List of Cycads Online Edition 2013–2023. Montgomery Botanical Center, Coral Gables, FL, USA. Available online: http://www.cycadlist.org (accessed on 12 January 2023).
- Condamine, F.L.; Nagalingum, N.S.; Marshall, C.R.; Morlon, H. Origin and diversification of living cycads: A cautionary tale on the impact of the branching process prior in Bayesian molecular dating. BMC Evol. Biol. 2015, 15, 65. [Google Scholar] [CrossRef] [PubMed] [Green Version]
- Hardy, G.E.; Sivasithamparam, K. Phytophthora spp. associated with container-grown plants in nurseries in Western Australia. Plant Dis. 1988, 72, 435–437. [Google Scholar] [CrossRef] [Green Version]
- Dart, N.L.; Riley, K.L.; Rugarber, E.F.; Castagner, G.A. Recovery frequency of Phytophthora ramorum and other Phytophthora spp. in the soil profile of ornamental retail nurseries. Plant Dis. 2007, 91, 1419–1422. [Google Scholar]
- Schwingle, B.W.; Smith, J.A.; Blanchette, R.A. Phytophthora species associated with diseased woody ornamentals in Minnesota nurseries. Plant Dis. 2007, 91, 97–102. [Google Scholar] [CrossRef] [Green Version]
- Moralejo, E.; Pérez-Sierra, A.M.; Álvarez, L.A.; Belbahri, L.; Lefort, F.; Descals, E. Multiple alien Phytophthora taxa discovered on diseased ornamental plants in Spain. Plant Pathol. 2009, 58, 100–110. [Google Scholar] [CrossRef]
- Leonberger, A.J.; Speers, C.; Ruhl, G.; Creswell, T.; Beckerman, J.L. A survey of Phytophtohora spp. in Midwest nurseries, greenhouses, and landscapes. Plant Dis. 2013, 97, 635–640. [Google Scholar] [CrossRef] [Green Version]
- Abad, Z.G.; Abad, J.A.; Cacciola, S.O.; Pane, A.; Faedda, R.; Moralejo, E.; Pérez-Sierra, A.; Abad-Campos, P.; Alvarez-Bernaola, L.A.; Bakonyi, J.; et al. Phytophthora niederhauserii sp. nov., a polyphagous species associated with ornamentals, fruit trees and native plants in 13 countries. Mycologia 2014, 106, 431–447. [Google Scholar] [CrossRef]
- Prigigallo, M.I.; Mosca, S.; Cacciola, S.O.; Cooke, D.E.L.; Schena, L. Molecular analysis of Phytophthora diversity in nursery-grown ornamental and fruit plants. Plant Pathol. 2015, 64, 1308–1319. [Google Scholar] [CrossRef] [Green Version]
- Jung, T.; Orlikowski, L.; Henricot, B.; Abad-Campos, P.; Aday, A.G.; Aguín Casal, O.; Bakonyi, J.; Cacciola, S.O.; Cech, T.; Chavarriaga, D.; et al. Widespread Phytophthora infestations in European nurseries put forest, semi-natural and horticultural ecosystems at high risk of Phytophthora diseases. For. Pathol. 2016, 46, 134–163. [Google Scholar] [CrossRef] [Green Version]
- Junker, C.; Goff, P.; Wagner, S.; Werres, S. Occurrence of Phytophthora species in commercial nursery production. Plant Health Prog. 2016, 17, 64–75. [Google Scholar] [CrossRef]
- Patel, J.S.; Vitoreli, A.; Palmateer, A.J.; El-Sayed, A.; Norman, D.J.; Goss, E.M.; Brennan, M.S.; Ali, G.S. Characterization of Phytophthora spp. isolated from ornamental plants in Florida. Plant Dis. 2016, 100, 500–509. [Google Scholar] [CrossRef] [PubMed] [Green Version]
- Riddell, C.E.; Frederickson-Matika, D.; Armstrong, A.C.; Elliot, M.; Forster, J.; Hedley, P.E.; Morris, J.; Thorpe, P.; Cooke, D.E.L.; Pritchard, L.; et al. Metabarcoding reveals a high diversity of woody host associated Phytophthora spp. in soils at public gardens and amenity woodlands in Britain. PeerJ 2019, 7, e6931. [Google Scholar] [CrossRef] [Green Version]
- Mora-Sala, B.; León, M.; Pérez-Sierra, A.; Abad-Campos, P. New reports of Phytophthora species in plant nurseries in Spain. Pathogens 2022, 11, 826. [Google Scholar] [CrossRef]
- Pane, A.; Allatta, C.; Sammarco, G.; Cacciola, S.O. First report of bud rot of Canary Island date palm caused by Phytophthora palmivora in Italy. Plant Dis. 2007, 91, 1059. [Google Scholar] [CrossRef]
- Faedda, R.; Pane, A.; Granata, G.; Magnano di San Lio, G. First report of Phytophthora nicotianae as pathogen of blue Mediterranean fan palm. New Dis. Rep. 2011, 23, 3. [Google Scholar] [CrossRef] [Green Version]
- Nesamari, R.; Coutinho, T.A.; Roux, J. Investigations into Encephalartos insect pests and diseases in South Africa and identification of Phythopthora cinnamomi as a pathogen of Modjiadi cycad. Plant Pathol. 2017, 66, 612–622. [Google Scholar] [CrossRef]
- NSW Department of Planning, Industry and Environment. Infection of Native Plants by Phytophthora Cinnamomi. Available online: https://www.environment.nsw.gov.au/savingourspeciesapp/project.aspx?ProfileID=20026 (accessed on 13 January 2023).
- Safaiefarahani, B.; Mostowfizadeh-Ghalamfarsa, R.; Hardy, G.; Burgess, T.I. Re-evaluation of the Phytophthora cryptogea species complex and the description of a new species, Phytophthora pseudocryptogea sp. nov. Mycol. Prog. 2015, 14, 108. [Google Scholar] [CrossRef]
- Martin, F.N.; Blair, J.E.; Coffey, M.D. Combined mitochondrial and nuclear multilocus phylogeny of the genus Phytophthora. Fungal Genet. Biol. 2014, 66, 19–32. [Google Scholar] [CrossRef]
- Abad, G.Z.; Burgess, T.; Redford, A.J.; Bienapfl, J.C.; Mathew, R.; Srivastava, S.K.; Jennings, K.C. IDphy: An international online resource for molecular and morphological identification of Phytophthora. Plant Dis. 2022, 10, 259. [Google Scholar] [CrossRef]
- Jung, T.; La Spada, F.; Pane, A.; Aloi, F.; Evoli, M.; Jung, M.H.; Scanu, B.; Faedda, R.; Rizza, C.; Puglisi, I.; et al. Diversity and distribution of Phytophthora species in protected natural areas in Sicily. Forests 2019, 10, 259. [Google Scholar] [CrossRef] [Green Version]
- Seddaiu, S.; Brandano, A.; Ruiu, P.A.; Sechi, C.; Scanu, B. An overview of Phytophthora species inhabiting declining Quercus suber stands in Sardinia (Italy). Forests 2020, 11, 971. [Google Scholar] [CrossRef]
- Bregant, C.; Mulas, A.A.; Rossetto, G.; Deidda, A.; Maddau, L.; Piras, G.; Linaldeddu, B.T. Phytophthora mediterranea sp. nov., a new species closely related to Phytophthora cinnamomi from nursery plants of Myrtus communis in Italy. Forests 2021, 12, 682. [Google Scholar] [CrossRef]
- Riolo, M.; La Spada, F.; Aloi, F.; Giusso del Galdo, G.; Santilli, E.; Pane, A.; Cacciola, S.O. Phytophthora diversity in a sentinel arboretum and in a nature reserve area. Biol. Life Sci. Forum 2021, 4, 51. [Google Scholar]
- La Spada, F.; Cock, P.J.A.; Randall, E.; Pane, A.; Cooke, D.E.L.; Cacciola, S.O. DNA metabarcoding and isolation by baiting complement each other in revealing Phytophthora diversity in anthropized and natural ecosystems. J. Fungi 2022, 8, 330. [Google Scholar] [CrossRef]
- Kurbetli, İ.; Woodward, S.; Aydoğdu, M.; Sülü, G.; Özben, S. Phytophthora plurivora and Phytophthora pseudocryptogea isolated from soils supporting declining oaks (Quercus robur L.) in İstanbul, Turkey. For. Pathol. 2022, 56, e12782. [Google Scholar]
- Cacciola, S.O.; Magnano di San Lio, G.; Greco, G.; Pane, A. Electrophoretic study of three related Phytophthora species. EPPO Bull. 1990, 20, 47–58. [Google Scholar] [CrossRef]
- Cacciola, S.O.; Pane, A.; Raudino, F.; Davino, S. First report of root and crown rot of sage caused by Phytophthora cryptogea in Italy. Plant Dis. 2002, 86, 1176. [Google Scholar] [CrossRef]
- Cacciola, S.O.; Chimento, A.; Pane, A.; Cooke, D.E.L.; Magnano di San Lio, G. Root rot of lantana caused by Phytophthora cryptogea. Plant Dis. 2005, 89, 909. [Google Scholar] [CrossRef]
- Cacciola, S.O.; Scibetta, S.; Martini, P.; Rizza, C.; Pane, A. Phytophthora taxon niederhauserii, a new root and crown pathogen of Banksia spp. in Italy. Plant Dis. 2009, 93, 1216. [Google Scholar] [CrossRef]
- Faedda, R.; Cacciola, S.O.; Pane, A.; Martini, P.; Odasso, M.; Magnano di San Lio, G. First report of Phytophthora taxon niehederhauserii causing root and stem rot of mimosa in Italy. Plant Dis. 2013, 97, 688. [Google Scholar] [CrossRef]
- Antonelli, C.; Biscontri, M.; Tabet, D.; Vettraino, A.M. The never-ending presence of Phytophthora species in Italian nurseries. Pathogens 2023, 12, 15. [Google Scholar] [CrossRef]
- Pane, A.; Martini, P.; Chimento, A.; Rapetti, S.; Savona, S.; Grasso, F.M.; Cacciola, S.O. Phytophthora species on ornamental plants in Italy. J. Plant Pathol. 2005, 87, 301. [Google Scholar]
- Pane, A.; Cacciola, S.O.; Chimento, A.; Allatta, C.; Scibetta, S.; Magnano di San Lio, G. First report of Phytophthora spp. as pathogens of Pandorea jasminoides in Italy. Plant Dis. 2008, 92, 313. [Google Scholar] [CrossRef]
- Rizza, C.; Faedda, R.; Pane, A.; Cacciola, S.O. First report of root and basal stem rot caused by Phytophthora nicotianae on tree aeonium (Aeonium arboreum) in Italy. Plant Dis. 2011, 92, 362. [Google Scholar] [CrossRef] [PubMed]
- Kamoun, S.; Furzer, O.; Jones, J.D.G.; Judelson, H.S.; Ali, G.S.; Dalio, R.J.D.; Roy, S.G.; Schena, L.; Zambounis, A.; Panabières, F.; et al. The top 10 oomycete pathogens in molecular plant pathology. Mol. Plant Pathol. 2015, 16, 413–434. [Google Scholar] [CrossRef] [PubMed]
- Migliorini, D.; Ghelardini, L.; Tondini, E.; Luchi, N.; Santini, A. The potential of symptomless potted plants for carrying invasive soilborne plant pathogens. Divers. Distrib. 2015, 21, 1218–1229. [Google Scholar] [CrossRef] [Green Version]
- Panabières, F.; Ali, G.S.; Allagui, M.B.; Dalio, R.J.D.; Gudmestad, N.C.; Kuhn, M.L.; Guha Roy, S.; Schena, L.; Zampounis, A. Phytophthora nicotianae diseases worldwide: New knowledge of a long-recognised pathogen. Phytopathol. Mediterr. 2016, 55, 20–40. [Google Scholar]
- Prigigallo, M.I.; Abdelfataah, A.; Cacciola, S.O.; Faedda, R.; Sanzani, S.M.; Cooke, D.E.L.; Schena, L. Metabarcoding analysis of Phytophthora diversity using genus-specific primers and 454 pyrosequencing. Phytopathology 2016, 196, 305–313. [Google Scholar] [CrossRef] [PubMed] [Green Version]
- Cacciola, S.O.; Pane, A.; Faedda, R.; Rizza, C.; Badalà, F.; Magnano di San Lio, G. Bud and root rot of windmill palm (Trachycarpus fortunei) caused by simultaneous infections of Phytophthora palmivora and P. nicotianae in Sicily. Plant Dis. 2011, 95, 769. [Google Scholar] [CrossRef] [PubMed]
- Baysal-Gurel, F.; Bika, R.; Simmons, T.; Avin, F. Identification and management of Phytophthora aerial blight caused by Phytophthora nicotianae on Catharanthus roseus. Plant Dis. 2022, 106, 1271–1277. [Google Scholar] [CrossRef] [PubMed]
- Biasi, A.; Martin, F.N.; Cacciola, S.O.; Magnano di San Lio, G.; Grünwald, N.G.; Schena, L. Genetic analysis of Phytophthora nicotianae populations from different hosts using microsatellite markers. Phytopathology 2016, 106, 1006–1014. [Google Scholar] [CrossRef] [PubMed] [Green Version]
- Faedda, R.; Cacciola, S.O.; Pane, A.; Szigethy, A.; Bakonyi, J.; Man In’t Veld, W.; Martini, P.; Schena, L.; Magnano di San Lio, G. Phytophthora × pelgrandis causes root and collar rot of Lavandula stoechas in Italy. Plant Dis. 2013, 97, 1091–1096. [Google Scholar] [CrossRef] [PubMed] [Green Version]
- Szigethy, A.; Nagy, Z.Á.; Vettraino, A.M.; Józsa, A.; Cacciola, S.O.; Faedda, R.; Bakonyi, J. First Report of Phytophthora × pelgrandis causing root rot and lower stem necrosis of common box, lavender and Port-Orford-cedar in Hungary. Plant Dis. 2013, 97, 152. [Google Scholar] [CrossRef]
- Cacciola, S.O.; Gullino, M.L. Emerging and re-emerging fungus and oomycete soil-borne plant diseases in Italy. Phytopathol. Mediterr. 2019, 58, 451–472. [Google Scholar]
- Puglisi, I.; De Patrizio, A.; Schena, L.; Jung, T.; Evoli, M.; Pane, A.; Van Hoa, N.; Van Tri, M.; Wright, S.; Ramstedt, M.; et al. Two previously unknown Phytophthora species associated with brown rot of pomelo (Citrus grandis) fruits in Vietnam. PLoS ONE 2017, 12, e0172085. [Google Scholar] [CrossRef] [Green Version]
- Scott, P.M.; Burgess, T.I.; Barber, P.A.; Shearer, B.L.; Stukely, M.J.; Hardy, G.E.; Jung, T. Phytophthora multivora sp. nov., a new species recovered from declining Eucalyptus, Banksia, Agonis and other plant species in Western Australia. Pers.-Mol. Phylogeny Evol. Fungi 2009, 22, 1–13. [Google Scholar] [CrossRef] [Green Version]
- Tsykun, T.; Prospero, S.; Schoebel, C.N.; Rea, A.; Burgess, T.I. Global invasion history of the emerging plant pathogen Phytophthora multivora. BMC Genom. 2022, 23, 153. [Google Scholar] [CrossRef]
- Riolo, M.; Aloi, F.; La Spada, F.; Sciandrello, S.; Moricca, S.; Santilli, E.; Pane, A.; Cacciola, S.O. Diversity of Phytophthora communities across different types of Mediterranean vegetation in a nature reserve area. Forests 2020, 11, 853. [Google Scholar] [CrossRef]
- Sims, L.L.; Garbelotto, M. Phytophthora species repeatedly introduced in Northern California through restoration projects can spread into adjacent sites. Biol. Invasions 2021, 23, 2173–2190. [Google Scholar] [CrossRef]
- Weiland, J.E. The challenges of managing Phytophthora root rot in the nursery industry. Plant Health Prog. 2021, 22, 332–342. [Google Scholar] [CrossRef]
- Masago, H.; Yoshikawa, M.; Fukada, M.; Nakanishi, N. Selective inhibition of Pythium spp. on a medium for direct isolation of Phytophthora spp. from soils and plants. Phytopathology 1977, 67, 425–428. [Google Scholar] [CrossRef]
- Erwin, D.C.; Ribeiro, O.K. Phytophthora Diseases Worldwide; APS Press—The American Phytopathological Society: St. Paul, MN, USA, 1996; pp. 84–95, 96–144, 456–463. [Google Scholar]
- Riolo, M.; Aloi, F.; Conti Taguali, S.; Pane, A.; Franco, M.; Cacciola, S.O. Phytophthora × cambivora as a major factor inciting the decline of European beech in a stand within the southernmost limit of its natural range in Europe. J. Fungi 2022, 8, 973. [Google Scholar] [CrossRef] [PubMed]
- Jung, T.; Blaschke, H.; Neumann, P. Isolation, identification and pathogenicity of Phytophthora species from declining oak stands. Eur. J. For. Pathol. 1996, 26, 253–272. [Google Scholar] [CrossRef]
- Jung, T.; Cooke, D.E.L.; Blaschke, H.; Duncan, J.M.; Oßwald, W. Phytophthora quercina sp. nov., causing root rot of European oaks. Mycol. Res. 1999, 103, 785–798. [Google Scholar] [CrossRef]
- Pane, A.; Cacciola, S.O.; Scibetta, S.; Bentivenga, G.; Magnano di San Lio, G. Four Phytophthora species causing foot and root rot of apricot in Italy. Plant Dis. 2009, 83, 844. [Google Scholar] [CrossRef]
- Mammella, M.A.; Cacciola, S.O.; Martin, F.; Schena, L. Genetic characterization of Phytophthora nicotianae by the analysis of polymorphic regions of the mitochondrial DNA. Fungal Biol. 2011, 115, 432–442. [Google Scholar] [CrossRef]
- Cooke, D.E.L.; Drenth, A.; Duncan, J.M.; Wagels, G.; Brasier, C.M. A molecular phylogeny of Phytophthora and related oomycetes. Fungal Genet. Biol. 2000, 30, 17–32. [Google Scholar] [CrossRef]
- White, T.J.; Bruns, T.; Lee, S.; Taylor, J.W. Amplification and direct sequencing of fungal ribosomal RNA genes for phylogenet-ics. In PCR Protocols: A Guide to Methods and Applications; Innis, M.A., Gelfand, D.H., Sninsky, J.J., White, T.J., Eds.; Academic Press Inc.: San Diego, CA, USA, 1990; Volume 18, pp. 315–322. [Google Scholar]
- Kroon, L.P.N.M.; Bakker, F.T.; Van Den Bosch, G.B.M.; Bonants, P.J.M.; Flier, W.G. Phylogenetic analysis of Phytophthora species based on mitochondrial and nuclear DNA sequences. Fungal Genet. Biol. 2004, 41, 766–782. [Google Scholar] [CrossRef] [PubMed]
- Aloi, F.; Riolo, M.; La Spada, F.; Bentivenga, G.; Moricca, S.; Santilli, E.; Pane, A.; Faedda, R.; Cacciola, S.O. Phytophthora root and collar rot of Paulownia, a new disease for Europe. Forests 2021, 12, 1664. [Google Scholar] [CrossRef]

| Species | Isolate Code | Source | Mating Type | Year of Isolation | Genbank Accession No. | ||
|---|---|---|---|---|---|---|---|
| ITS | TUB | COI | |||||
| P. pseudocryptogea | CIPH | Stem | A1 | 2010 | HM627524 | OP629924 | OP563125 |
| CIPH2 | OP557985 | OP629925 | OP563126 | ||||
| CIPH3R | Roots | OP557986 | OP629926 | OP563127 | |||
| CIPH4R | OP557987 | OP629927 | OP563128 | ||||
| CycS1 | Stem | 2021 | OP557988 | OP629928 | OP563129 | ||
| CycS2 | OP557989 | OP629929 | OP563130 | ||||
| CycR1 | Roots | OP557990 | OP629930 | OP563131 | |||
| CycR2 | OP557991 | OP629931 | OP563132 | ||||
| CycC14R | Rhizosphere soil | OP557992 | OP629932 | OP563133 | |||
| CycC15R | OP557993 | OP629933 | OP563134 | ||||
| P. multivora | CycC2 | H a | OP557994 | OP629934 | OP563135 | ||
| CycC3 | OP557995 | OP629935 | OP563136 | ||||
| CycC4 | OP557996 | OP629936 | OP563137 | ||||
| P. nicotianae | CycC11R | A2 | OP557997 | OP629937 | OP563138 | ||
| CycC12R | OP557998 | OP629938 | OP563139 | ||||
| CycC13R | A1 | OP557999 | OP629939 | OP563140 | |||
Disclaimer/Publisher’s Note: The statements, opinions and data contained in all publications are solely those of the individual author(s) and contributor(s) and not of MDPI and/or the editor(s). MDPI and/or the editor(s) disclaim responsibility for any injury to people or property resulting from any ideas, methods, instructions or products referred to in the content. |
© 2023 by the authors. Licensee MDPI, Basel, Switzerland. This article is an open access article distributed under the terms and conditions of the Creative Commons Attribution (CC BY) license (https://creativecommons.org/licenses/by/4.0/).
Share and Cite
Aloi, F.; Parlascino, R.; Conti Taguali, S.; Faedda, R.; Pane, A.; Cacciola, S.O. Phytophthora pseudocryptogea, P. nicotianae and P. multivora Associated to Cycas revoluta: First Report Worldwide. Plants 2023, 12, 1197. https://doi.org/10.3390/plants12051197
Aloi F, Parlascino R, Conti Taguali S, Faedda R, Pane A, Cacciola SO. Phytophthora pseudocryptogea, P. nicotianae and P. multivora Associated to Cycas revoluta: First Report Worldwide. Plants. 2023; 12(5):1197. https://doi.org/10.3390/plants12051197
Chicago/Turabian StyleAloi, Francesco, Rossana Parlascino, Sebastiano Conti Taguali, Roberto Faedda, Antonella Pane, and Santa Olga Cacciola. 2023. "Phytophthora pseudocryptogea, P. nicotianae and P. multivora Associated to Cycas revoluta: First Report Worldwide" Plants 12, no. 5: 1197. https://doi.org/10.3390/plants12051197





